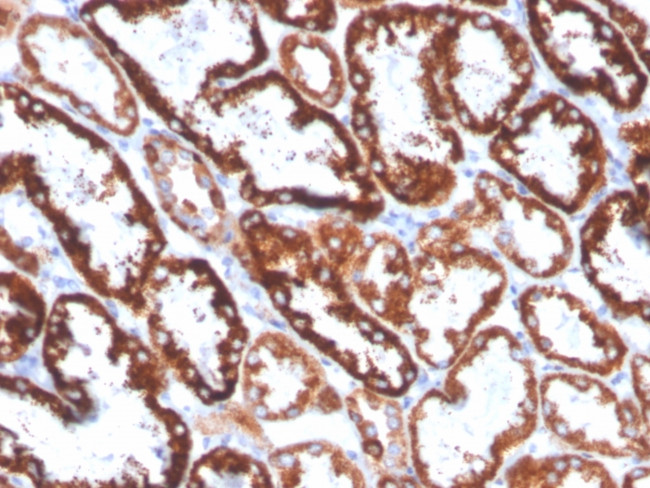
FGF23 (Fibroblast Growth Factor 23) Antibody in Immunohistochemistry (Paraffin) (IHC (P))

Search
NeoBiotechnologies
FGF23 (Fibroblast Growth Factor 23) Monoclonal Antibody (FGF23, 4168)
{{$productOrderCtrl.translations['antibody.pdp.commerceCard.promotion.promotions']}}
{{$productOrderCtrl.translations['antibody.pdp.commerceCard.promotion.viewpromo']}}
{{$productOrderCtrl.translations['antibody.pdp.commerceCard.promotion.promocode']}}: {{promo.promoCode}} {{promo.promoTitle}} {{promo.promoDescription}}. {{$productOrderCtrl.translations['antibody.pdp.commerceCard.promotion.learnmore']}}
产品信息
8074-MSM8-P1ABX
种属反应
宿主/亚型
分类
类型
克隆号
抗原
偶联物
形式
浓度
规格
纯化类型
保存液
内含物
保存条件
运输条件
产品详细信息
Immunohistochemistry (PFA fixed): incubate antibody for 30 min RT. Staining of formalin-fixed tissues requires heating tissue sections in 10mM Tris with 1mM EDTA, pH 9.0, for 45 min at 95 degrees C followed by cooling at RT for 20 minutes.
靶标信息
The protein encoded by this gene is a member of the fibroblast growth factor family. FGF family members possess broad mitogenic and cell survival activities and are involved in a variety of biological processes including embryonic development, cell growth, morphogenesis, tissue repair, tumor growth and invasion. The product of this gene inhibits renal tubular phosphate transport. This gene was identified by its mutations associated with autosomal dominant hypophosphatemic rickets, an inherited phosphate wasting disorder. Abnormally high level expression of this gene was found in oncogenic hypophosphatemic osteomalacia, a phenotypically similar disease caused by abnormal phosphate metabolism. Mutations in this gene have also been shown to cause familial tumoral calcinosis with hyperphosphatemia.
仅用于科研。不用于诊断过程。未经明确授权不得转售。
篇参考文献 (0)
生物信息学
蛋白别名: FGF; FGF-23; Fibroblast growth factor; Fibroblast growth factor 23; Phosphatonin; tumor-derived hypophosphatemia inducing factor; Tumor-derived hypophosphatemia-inducing factor
基因别名: ADHR; FGF23; FGFN; HFTC2; HPDR2; HYPF; PHPTC; UNQ3027/PRO9828
UniProt ID: (Human) Q9GZV9
Entrez Gene ID: (Human) 8074